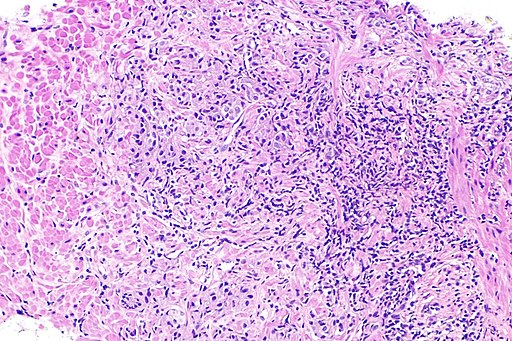

Prostatitida – Wikipedie
Prostatitida je zánět předstojné žlázy, spíše známé pod názvem prostata. Jedná se o nejčastější urologický problém mužů do 50 let. [1 ] Mezi její symptomy patří horečka, zimnice, dysurie či sexuální poruchy.
Prostatitis - Wikipedia
Prostatitis is an umbrella term for a variety of medical conditions that incorporate bacterial and non-bacterial origin illnesses in the pelvic region.
Prostatitida - příznaky, léčba, důsledky, prevence
Muži, možná si myslíte, že problémy s prostatou jsou známkou toho, že čas pokročil. Většina z vás si možná myslí, že problémy s prostatou u mužů jsou jako menop
Zboží.cz›Prostatitis
Prostovit 30 ml
Prostovit zlepšuje fungování mužského reprodukčního systému. Obsahuje zcela přírodní formuli, která aktivně podporuje dobrou úroveň libida a zdraví prostaty.
890 Kč
v 1 obchodě
Zánět prostaty (prostatitida) | Renaissance
Zánět prostaty (prostatitida): popis diagnózy, postup léčby a studie o působení magnetoterapie. Více na webu...
Prostatitida neboli zánět prostaty | Superionherbs
Prostatitida je akutní nebo chronický (většinou bakteriální) zánět prostaty, který je nejčastějším urologickým problémem mužů do 50 let.
Zánět prostaty (Prostatitis) - Obchod Čínské Medicíny
Zánět prostaty (Prostatitis), Obchod Čínské Medicíny
Zánět prostaty (prostatitida): Projevy a řešení | Uniprosta
Existuje chronický a akutní zánět prostaty. V čem se liší? Jaké jsou jejich projevy a příznaky? A jak je léčit? Přečtěte si více v článku.
Prostatitis chronica | uLékaře.cz
V první fázi se obvykle objevuje občasný výtok z močové trubice, svědění, nepříjemné močení nebo bolestivé domočení. Později to bývá nejčastěji nadýmání, bolest hráze podbřišku nebo varlat, občasné vzestupy tělesné teploty nebo snížená chuť…
Videa›Prostatitis
PROSTATITIS.
28. 1. 2011
Prostatitis
1. 2. 2019
What are the symptoms of prostatitis?
14. 2. 2012
Prostatitis
1. 10. 2016
Prostata - Dr. Popov
Častější nucení na močení během dne, časté močení v noci, oslabený proud moči, přerušované močení s pocitem neustálého vyprázdnění, odkapávání moči po vymočení.
Neobsahuje prostatitisMusí obsahovat prostatitis
Nabídky ze Zboží.cz
Skladem
589 Kč
Wellness4you.cz
Prostatitida je zánět předstojné žlázy, spíše známé pod názvem prostata. Jedná se o nejčastější urologický problém mužů do 50 let. Mezi její symptomy patří horečka, zimnice, dysurie či sexuální poruchy. K léčbě jsou indikována antibiotika. Rozlišujeme následující typy prostatitidy: akutní prostatitida chronická bakteriální prostatitida chronická prostatitida - syndrom… Wikipedie
odkazuje na služby nejen od Seznam.cz.
© 1996–2025 Seznam.cz, a.s.